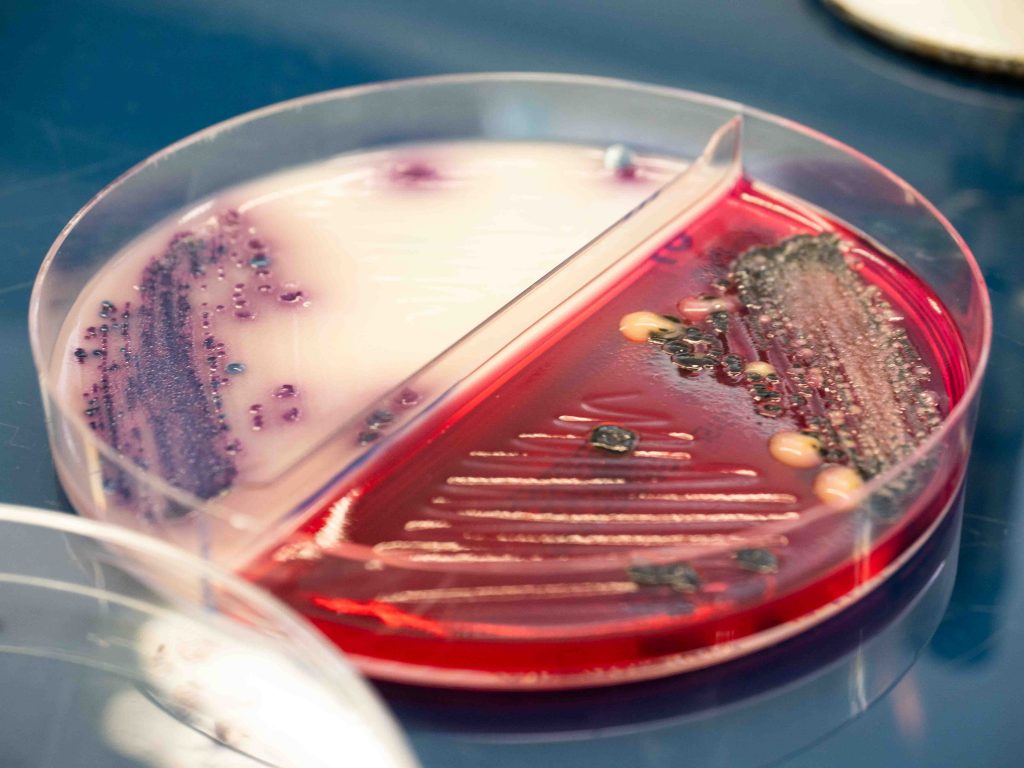
Analyse des surfaces hospitalières hygiène hospitalière microbiologie par Laboratoire QUALYSE

français
Anticiper les contaminations pour mieux protéger les patients et prévenir les infections
Dans l’environnement hospitalier, chaque micro-organisme compte. La qualité microbiologique des installations impacte directement la sécurité des patients et des équipes. QUALYSE vous aide à détecter, maîtriser et prévenir les risques de contamination. Nos équipes interviennent sur l’ensemble de la chaîne d’hygiène hospitalière pour assurer la qualité microbiologique de vos environnements et la sécurité des patients. Différents types de contrôle permettent la maitrise du risque en milieu hospitalier comme la qualification opérationnelle, la requalification périodique, le contrôle de routine.


Les prestations QUALYSE et analyses en microbiologie en hygiène hospitalière


L’air
La qualité de l’air est essentielle dans les zones à environnement maîtrisé (blocs opératoires, salles blanches, réanimations, ESET).
Qualyse effectue :

Les surfaces


Les eaux hospitalières
Contrôle de la qualité des différentes catégories d’eaux en établissement de santé


Les dispositifs médicaux
Evaluation de la qualité microbiologique de toute nature d’endoscopes : gastroscope, duodénoscope, bronchoscope… par prélèvement global, canal par canal selon besoin, et vérification du volume récupéré : micro-organismes revivifiables, identification des germes indicateurs : Staphylococcus aureus, Pseudomonas spp., Candida sp., Acinetobacter sp., Stenotrophomonas maltophilia, entérobactéries…


Des prestations conformes aux normes et délais maîtrisés
Toutes les analyses sont effectuées selon les référentiels en vigueur (normes AFNOR, ISO, Pharmacopée Européenne) avec des délais de 1 à 12 jours selon les paramètres.
QUALYSE garantit fiabilité, traçabilité et accompagnement technique dans l’interprétation des résultats.




